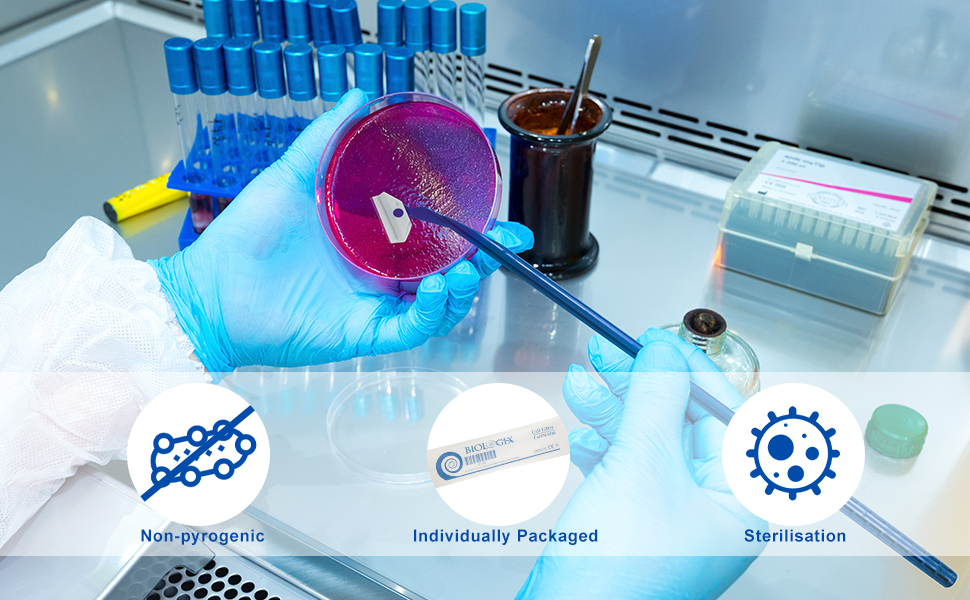

Customer Services
Copyright © 2025 Desertcart Holdings Limited
Desert Online General Trading LLC
Dubai, United Arab Emirates


CryoKing Biologix Cell Scraper, Handle Length 18cm, Individual Package, Polyethylene, Case of 100

Trustpilot
2 weeks ago
2 days ago
1 month ago
2 months ago